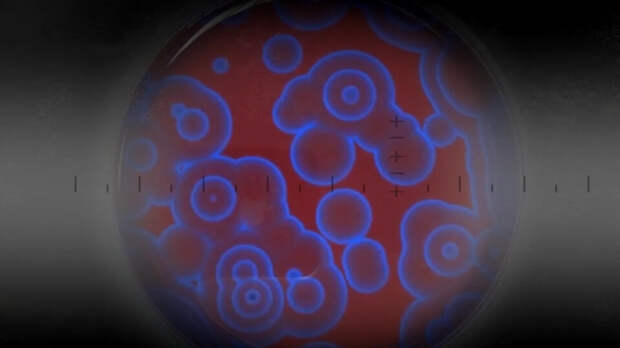

скриншот видео
скриншот видео
Несколько минут в капсуле – и человек абсолютно здоров. Много лет именно так показывали будущее медицины в фантастических фильмах. И оно наконец наступило. Более того, возможно, что скоро врачи смогут лечить человека до того, как он заболел.
Как стульчак для унитаза способен предотвратить инфаркт?
Каким образом красители помогают бороться с онкологией? И чем полезна швейцарская капсула? Об этом рассказывает программа "Наука и техника" с Михаилом Борзенковым на РЕН ТВ.Лечебная капсула
В Швейцарии разработали лечебную капсулу. Этот удивительный аппарат способен моментально ставить самые сложные диагнозы и тут же лечить болезни.
"Эти голографические медицинские станции управляются искусственным интеллектом. Компьютер выбирает из базы данных нужную операцию и с помощью ультратонких лазерных разрезов ее выполняет. В капсуле можно провести лапароскопию, вырезать аппендицит, восстановить органы и даже кожу после ожогов. При этом вы не испытываете никакой боли и не облучаетесь, а просто погружаетесь в глубокий сон", – объяснил доктор философии в области клинической нейропсихологии университета Айовы Джастин Файнштейн.
После лечения в капсуле пациент просыпается не только здоровым, но еще и помолодевшим на пару десятков лет. Морщины разглаживаются, зрение улучшается, суставы перестают хрустеть, и спина больше не болит. А все благодаря технологиям квантовой медицины: аппарат воздействует на едва уловимое электромагнитное излучение организма, и это позволяет буквально повернуть время вспять.
Вот только эта лечебная капсула – пока лишь проект. Когда чудо-техника станет доступна для пациентов, неизвестно.
Водолазка для мониторинга здоровья
Сходить к врачу, получить направление, провести кучу времени в очереди, попасть на УЗИ – все эти утомительные процедуры могут остаться в прошлом. Теперь можно просто надеть специальную водолазку.
 скриншот видео
скриншот видео "Эта одежда мониторит все жизненно важные функции организма. Сенсорные полоски соприкасаются с кожей через множество отверстий, а 30 датчиков передают показатели в съемный модуль с микропроцессором. Сам модуль крепится на человеке сбоку и работает на обычных литиевых батарейках", – говорит доцент кафедры медиаискусства и наук медиалаборатории Массачусетского технологического института Канан Дагдевирен.
Кофта контролирует температуру, сердцебиение и следит за работой внутренних органов. Ее можно носить каждый день и даже стирать.
Стульчак для предотвращения инфаркта
Ученые из Рочестера решили, что на страже здоровья должна стоять не одежда, а то, что никогда не выходит из моды, и создали стульчак для унитаза, который способен предотвратить инфаркт.
"Электроды на поверхности сидения измеряют работу сердца и сердечно-сосудистой системы. А четыре стойки с обратной стороны определяют уровень насыщенности крови кислородом. Такое сидение выявляет изменения в организме прежде, чем пациенты понимают, что чувствуют себя хуже", – поделился подробностями разработчик "умной" крышки для унитаза Николас Конн.
Чтобы устройство начало проверку организма, нужно просто присесть на стульчак и подождать пару секунд. Система сама измерит все нужные показатели и, если что-то пойдет не так, сообщит врачу. Только одно "но": сиденье может диагностировать исключительно заболевания сердца. А как бы хотелось сделать комплексный анализ всего за пару секунд.
 скриншот видео
скриншот видео Диагностика по капле крови
Молодая американка Элизабет Холмс сколотила миллиардное состояние на крови в прямом смысле слова. Женщина заявила, что разработала инновационную технологию, которая позволяет делать полный анализ крови всего по одной ее капле. Молодой изобретательнице поверили миллионы, но медицинский прорыв оказался всего лишь громкой аферой – результаты писали наобум. После того как обман раскрылся, Холмс отправили в тюрьму на 11 лет.
Тем не менее диагностика по капле крови вовсе не утопия. То, что не удалось скандально известной американке, смогли сделать ученые из Самары. Совсем скоро человечество сможет отказаться от страшных шприцов и игл при сдаче анализа крови. Для получения полного и точного результата достаточно будет всего лишь легкого укола пальца.
"Этот новый способ диагностики использует информацию о том, как свет взаимодействует с тканями и жидкостями организма. То есть возможно взять каплю крови у пациента для анализа, направить на нее лазерный луч, и, в зависимости от того, какой химический состав у этой капли крови, свет будет по-разному реагировать", – пояснил заведующий научно-исследовательской лабораторией "Фотоника" Самарского университета Иван Братченко.
Свет помогает распознавать болезни благодаря особой базе данных, которую собрали ученые из Самары. Искусственный интеллект сравнивает с ней результаты исследования, и это позволяет поставить точный диагноз.
"Мы получаем образцы от большого количества пациентов с разными болезнями и от здоровых людей. Записываем спектр и потом на основании статистического анализа можем понять, какие спектры характерны для больных людей, причем с какой-то конкретной болезнью", – подчеркнул Братченко.
Технология позволяет за считанные минуты выявить смертельно опасные болезни, в том числе онкологию. В обычных лабораториях на подобные анализы требуется несколько дней. Получается, диагностика по капле крови позволяет выиграть время и быстрее обратиться к врачу. Но ведь потом пациенту придется проходить через серию мучительных процедур.
 скриншот видео
скриншот видео Борьба с раком при помощи красителя
Ученые из Иванова уверены, что это совсем не обязательно. Они придумали, как можно победить опухоль при помощи красителя. В этом помогут особые флуоресцентные молекулы – люминофоры. Они вступают в реакцию с пораженными клетками и заставляют их светиться, чтобы было проще диагностировать болезнь. После этого вещество уничтожает пораженные клетки активным кислородом.
"Раковые клетки обладают большей кислотностью и полярностью. Поэтому при помещении данного соединения в клетку соединение будет менять свои свойства. Потенциально тераностики могут бороться не только с раковыми клетками, но еще с бактериальными патогенами. Благодаря облучению светом определенной длины волны генерируются активные формы синглетного кислорода, которые как раз и уничтожают патогенные клетки и микроорганизмы", – рассказал кандидат химических наук, младший научный сотрудник Института химии растворов имени Г.А. Крестова РАН Александр Калягин.
скриншот видео
скриншот видео Микроэлемент вечной молодости
Ученые из Иркутска предлагают бороться с болезнями, которые еще не начались. Самый эффективный способ – отсрочить старость. Специалисты разработали вещество на основе селена. В медицине его называют микроэлементом вечной молодости.
"Данные соединения являются высокоэффективными антиоксидантами и защищают клетки от окислительного стресса, то есть повреждения кислорода его активными формами. Они будут эффективны от возрастных изменений, токсических поражений и эффектов. Соединение может использоваться в качестве профилактики таких заболеваний, как болезнь Альцгеймера, Паркинсона, онкологических заболеваний, поскольку они вызваны тем самым окислительным стрессом", – отметил ведущий научный сотрудник лаборатории халькогенорганических соединений ИРИХ СО РАН Максим Мусалов.
Антиоксидант уже испытали на мышах, и грызуны действительно стали здоровее. Когда препарат пройдет все необходимые испытания, человек сможет принимать селен вместо обычных витаминов. И никакая капсула для лечения всех болезней просто не понадобится.
О самых невероятных достижениях прогресса, открытиях ученых, инновациях, способных изменить будущее человечества, смотрите в программе "Наука и техника" с ведущим Михаилом Борзенковым на РЕН ТВ.
Свежие комментарии